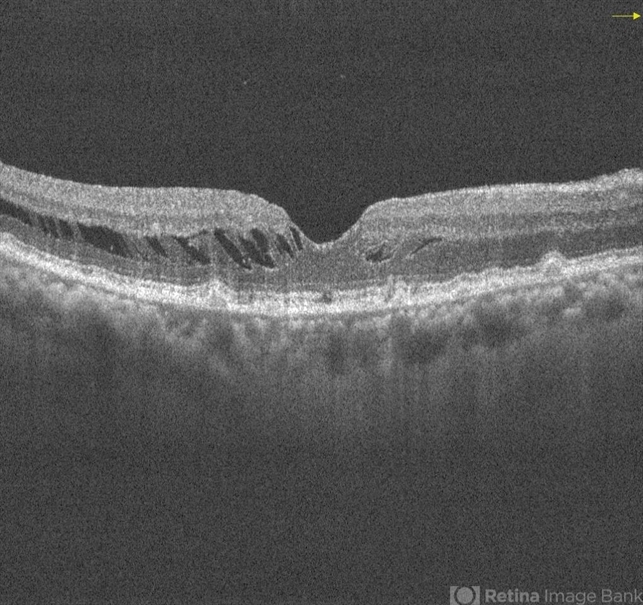

-
 By Ogugua Ndubuisi Okonkwo, MD, FRCS (Edin), FASRS
By Ogugua Ndubuisi Okonkwo, MD, FRCS (Edin), FASRS
Eye Foundation Retina Institute
Co-author(s): Adekunle Hassan MD; Olufemi Oderinlo MD - Uploaded on Feb 7, 2018.
- Last modified by Chayal Patel on Feb 13, 2018.
- Rating
- Appears in
- Miscellaneous
- Condition/keywords
- drusenoid deposit, vitreomacular traction (VMT)
- Photographer
- Oreoluwa, Eye Foundation Retina Institute . Lagos
- Imaging device
- Optical coherence tomography system
- Description
- Right eye one month post-operative OCT showing VMT release with return of the foveal depression and good vision. There is marked reduction in intra retina schisis and preserved outer retina layers.

Initializing download.
Initializing download.










